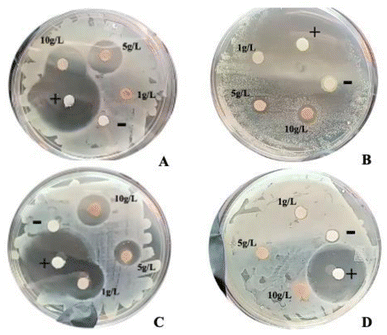
image file: d5fb00535c-f1.tif

Evaluation of condensed tannins from coffee pulp (Coffea arabica) as a natural preservative: study in a model food
Received
28th August 2025
, Accepted 2nd November 2025
First published on 19th November 2025
Abstract
The present study was designed to evaluate the antimicrobial capacity of condensed tannins, extracted and purified from coffee pulp (Coffea arabica), for use as a natural preservative in food industry products. Condensed tannins were extracted from coffee pulp residues by Ultrasound-Assisted Extraction (UAE) and purified by open column chromatography with Sephadex LH-20. First, the in vitro antimicrobial evaluation was performed with the disc diffusion method (1, 5 and 10 g L−1) against bacteria such as Escherichia coli, Salmonella typhimurium, Staphylococcus aureus and Listeria monocytogenes causing various foodborne diseases (FBDs). The qualitative analysis showed the presence of tannins in the acetone fraction purified and showed inhibitory activity at 10 g L−1 against S. typhi, S. aureus, and L. monocytogenes. No inhibition was observed against E. coli, highlighting its relative resistance under these conditions. To evaluate its efficacy as a food preservative, a corn-based model food typical of the north-central region of Mexico (bocoles) was formulated by incorporating the purified tannins at a concentration of 10 g L−1. The formulation consisted of adding lard, salt and black beans or cottage cheese to the corn dough. The tannins were incorporated during the kneading stage. This ensured a homogeneous distribution of the compound in the final product, which was pre-cooked and packaged in vacuum-sealed polypropylene bags. The effect of condensed tannins on shelf life was compared with a control group (no food preservative) and a group treated with a commercial synthetic preservative (potassium sorbate and sodium benzoate). The results showed a statistically significant difference between the groups, indicating that the condensed tannins prolonged the shelf life of the bocoles in a manner comparable to the synthetic preservative. This study demonstrates the potential of condensed tannins as natural food preservatives and presents them as a viable and functional alternative to replace synthetic additives in the food industry, which have been associated with adverse health effects from prolonged consumption. Significantly, this finding highlights the impact it will have on the development of safer products in the food industry that meet consumer demand for natural ingredients.
Sustainability spotlight
The increasing demand for safe and stable foods has traditionally led to the use of synthetic preservatives, which raise health and environmental concerns. This study explores condensed tannins extracted from coffee pulp, an agro-industrial by-product, as natural preservatives in a model food system. This strategy contributes to sustainability by reducing waste, valorizing agro-industrial residues, and offering an alternative to synthetic additives. Beyond promoting responsible production and consumption in line with the United Nations Sustainable Development Goal (SDG) 12, this work also supports SDG 3 (Good Health and Well-being) by offering safer food preservation strategies, SDG 6 (Clean Water and Sanitation) through reduced agro-industrial pollution and SDG 13 (Climate Action) by mitigating greenhouse gas emissions from agro-waste decomposition.
|
1. Introduction
Coffee pulp, a major by-product of the coffee industry, remains largely underutilized. Its accumulation contributes to environmental pollution and represents a missed opportunity for valorization within a circular economy framework.1 One reason is that this plant material has low biodegradability due to high levels of anti-nutritional compounds such as caffeine and some polyphenols, including tannins. Condensed tannins are molecules with complex structures that have various biological activities such as antioxidant, anticarcinogenic and antimicrobial properties.2 This last characteristic suggests that condensed tannins could be used as a natural preservative in food matrices.3 Previous studies have shown that coffee pulp and its derivatives, particularly condensed tannins, have significant antimicrobial activity against several food-borne pathogens. For example, proanthocyanidin-rich extracts of coffee pulp have shown inhibitory activity against Staphylococcus aureus, Listeria monocytogenes and Escherichia coli, among others, depending on the extraction method and concentration used.4,5 The antimicrobial effect is attributed to the ability of condensed tannins to disrupt microbial cell walls, chelate metal ions essential for bacterial growth and inhibit extracellular enzymes.6
Synthetic preservatives such as sodium benzoate and potassium sorbate are widely used in the food industry for their efficacy against yeasts, fungi and certain bacteria. However, prolonged exposure to these compounds has raised concerns about their potential toxicological and allergenic effects, including associations with cell damage, behavioral changes and hypersensitivity reactions in sensitive individuals.7 In contrast, natural preservatives derived from plant sources, such as condensed tannins from coffee pulp, offer a safer alternative, combining antimicrobial and antioxidant properties with biodegradability and consumer acceptance.
The food industry strives to offer products with extended shelf life, employing preservation strategies such as the use of commercial preservatives, optimized packaging systems, and accurate shelf-life predictions.8 Therefore, the food industry must report the information necessary to determine the shelf life of its products within a relatively short period of time to meet the needs of consumers.
Shelf life refers to the period during which a food product maintains acceptable sensory, nutritional, and safety attributes. The prediction of shelf-life at an optimal time is something that the food industry has demanded in recent years, so accelerated shelf life testing is an excellent option to meet this need. This is mainly based on the results of tests performed at regular intervals.9 Tests are used when the study quality index reaches the limit after storage at a real temperature of its storage (two or three temperatures), based on the data obtained, the prediction is made by implementing the Arrhenius model.10 Therefore, the main objective of this study was to evaluate the use of condensed tannins extracted from coffee pulp (Coffea arabica) as a natural preservative to improve the shelf life of a model food.
2. Materials and methods
2.1 Collection and preparation of the plant material
Fresh coffee pulp was collected in Xilitla, S.L.P., Mexico (August 2022), and immediately transported to the Food Research Laboratory (FEPZH-UASLP). The material was dehydrated in a conventional oven at 40 °C for 72 hours, ground into a fine powder, and stored in airtight, light-protected containers until further use.
2.2 Ultrasound-assisted extraction (UAE) of condensed tannins
The recovery of condensed tannins was carried out according to the methodology described by Ramirez-Coronel et al., (2004)11 and Wong-Paz et al. (2021).1 The extraction was performed using 1 L of aqueous acetone as solvent (70% v/v) and 100 g dried coffee pulp. The method implemented was by sonication in a Branson ultrasonic bath at 40 kHz and room temperature for 10 minutes. The acetone extract was filtered with Whatman No. 1 filter paper and concentrated by vacuum evaporation at 50 °C.
2.3 Purification of condensed tannins using a Sephadex LH-20 column
The recovery of condensed tannins from crude extracts was performed using the Sephadex LH-20 method.12,13 First, the concentrated crude extracts were passed through Sephadex LH-20 (previously equilibrated with water). Subsequently, elution was performed on the column using the following solvents: water (400 mL); ethanol (350 mL) and aqueous acetone (70%, v/v) (300 mL) to obtain a condensed tannin-rich fraction and finally recovered manually with each solvent. The acetone fraction was rotaevaporated to remove the organic solvent, subjected to drying (40 °C, 24 h) and then stored in vials for further application.
2.4 Determination of condensed tannins (HCl-butanol assay)
Condensed tannins were quantified using the HCl-butanol method.14 A reaction mixture of 250 µL sample, 1.5 mL HCl-butanol, and 50 µL ferric reagent was prepared, vortexed, and incubated in a 95 °C water bath for 40 minutes. Absorbance was measured at 550 nm after cooling. Concentrations were calculated using a calibration curve prepared with procyanidin C1 as the standard (Wong-Paz et al., 2021).1
2.5 Evaluation of the antibacterial capacity of condensed tannins against foodborne pathogenic bacteria
To evaluate the antibacterial capacity of the condensed tannins purified, three solutions were prepared with ethanol (3%, v/v/) at concentrations of 1, 5 and 10 g L−1. These were tested during the assays against common foodborne pathogenic bacteria, which were provided by the Food Research Laboratory of the FEPZH-UASLP and correspond to the collection of microorganisms of the State Public Health Laboratory (COEPRIS). Four strains were used: Salmonella typhimurium (ATCC 14028), Staphylococcus aureus (ATCC 25923), Listeria monocytogenes (ATCC 19115) and Escherichia coli (ATCC 25292), which were inoculated in 5 mL of nutrient broth and incubated at 35 °C for 24 h for revitalization. Once the bacteria were reactivated, they were inoculated on Mueller–Hinton agar plates and incubated at 35 °C for 24 h. Subsequently, inoculum batches were taken and transferred to glass tubes with 5 mL of saline solution (0.85%) until reaching a turbidity of nearly 0.5 based on the MacFarland scale (1.5 × 108 CFU mL−1) measured with an Ultrospec TM10 spectrophotometer. Finally, the determination of antibacterial activity against the bacteria was carried out using the disc diffusion method in triplicate. Mueller–Hinton agar plates were prepared and inoculated with the previously adjusted suspension of each inoculum over the entire surface (lawn), using a sterile swab. Then, sterile filter paper discs impregnated with the above concentrations of the purified condensed tannins were placed on a Petri dish. After 15 min of resting, the inoculated plates were incubated at 35 °C for 24 h. Ethanol (3%, v/v) was used as a negative control and ampicillin (5 g L−1) as a positive control. After 24 h of incubation, the radius of the inhibition halos was measured and expressed in mm of inhibition.15
2.6 Processing of the model food
The model food for this study was a bocol, an endemic food from Huasteca Potosina, which is a central-eastern popular region of Mexico. Bocol is a corn derivative, basically a thick tortilla made of corn dough mixed with lard and additional ingredients such as beans, coriander and cottage cheese, among others. In this study, thirty-six bocoles were prepared with the same base formulation. The base formulation used was as follows: corn dough (778.00 g), lard (105.00 g), salt (15.60 g). An additional ingredient was used, resulting in three types of bocoles: natural (without additional ingredient), beans (140.00 g) and cottage cheese (136.00 g). For bocol preparation, the dough was kneaded until a single homogeneous mixture was formed, and later the corresponding preservative was added. In each kind of bocol, three treatments were explored: (a) natural food preservative (condensed tannins), (b) commercial food preservative (sodium benzoate and potassium sorbate at 0.075% and 0.15%) and (c) without preservative. Subsequently, dough discs were made with 25 g of each dough, which were manually molded, and bocoles were obtained with a diameter of 5 cm and a thickness of 5 mm. The bocoles were precooked at a temperature of 75 °C for 5 minutes on each side. Afterwards, they were cooled at room temperature for 1 hour before being packaged.
2.7 Choice of suitable packaging
The selection of the packaging was made by means of food stability graphs according to Badui (2006).16 To obtain the necessary data and to identify the type of packaging material, pH, water activity (aW) and moisture content (% H) analyses were carried out on all formulated bocoles, including the control group (without preservative), the group with synthetic preservatives (potassium sorbate and sodium benzoate) and the group with condensed tannins. Measurements were carried out using a calibrated pH potentiometer, a water activity meter and an oven-dry moisture balance, respectively. Each analysis was performed in triplicate to ensure the accuracy of the results and was performed at different points in the feed to ensure the representativeness of the sample.
2.8 Experimental design for determining shelf life
The necessary conditions and parameters were established to evaluate the shelf life of three types of bocoles (natural, beans and cottage cheese) produced in the Food Technology Pilot Plant of the Faculty of Chemical Sciences of the UASLP. The study was carried out under three storage conditions (2 °C, 15 °C and 29 °C) and was monitored from the beginning of the experiment, from day 0 to day 15, for each type of bocol and for the three treatments applied (without preservative, with synthetic preservative and with condensed tannins).
2.9 Response variables
Samples of the bocoles were collected on days 0, 3, 6, 9, 12 and 15 of storage to obtain 5 samples. For each sample, the following analyses were determined: pH, aW and H (moisture%) for subsequent statistical analysis.
2.10 Application of the Arrhenius equation for shelf-life determination
The data obtained in the previous section were organized in tables according to the established conditions of time, temperature and measured parameters (pH, aW and % H).
The data were analyzed in the following order: (a) the average temperatures of each incubator were adjusted for kinetic calculations, (b) the reaction order was determined for each phenomenon studied (aW, pH, and % H), (c) the reaction order and its respective value of k (rate constant) were obtained, and the calculation of Ea was made using the Arrhenius equation and finally, the equation was adjusted by means of least squares.
The equations used were as follows:
| | | t0 = (initial day + initial hour) × 24 | (1) |
| | | tadjusted = (day + hour) × 24 − t0 | (2) |
| |  | (4) |
| |  | (5) |
| |  | (6) |
| |  | (7) |
| |  | (8) |
| |  | (9) |
General equation of activation energy:
| |  | (10) |
t0 = time zero,
adjusted = time adjusted, Δ
t = temperature difference,
Tln = logarithmic mean temperature,
Ft = time factor,
Treal = real temperature,
k = speed constant,
Ea = activation energy, and
R = ideal gas constant
3. Results and discussion
3.1 Extraction and purification of condensed tannins with Sephadex LH-20
It is known that the main difficulty in working with condensed tannins is their complexity due to their chemical structure; therefore, purification was carried out by liquid chromatography with a Sephadex LH-20 column. Based on the findings reported by Wong-Paz et al. (2021),1 the total condensed tannin content was determined exclusively in the acetone fraction, which they characterized and found to have a high concentration of procyanidins (≥98%) in coffee pulp. The total content of condensed tannins in the purified acetone fraction was 6.17 mg procyanidin equivalents (PC1) per gram of dry fraction, which was determined by the HCl-butanol assay. Although direct comparison with other studies is limited due to differences in extraction methods, expression units and reference standards, it is possible to establish some context. For example, Myo and Khat-udomkiri (2022)17 reported a tannin content of 4.5 mg of tannic acid equivalents per gram of dried coffee pulp, while Alkaltham, Salamatullah, and Hayat (2020)18 reported 0.18 mg of gallic acid equivalents per gram of dried coffee. Once the presence of condensed tannins in the acetone fraction was determined, it was rotaevaporated to eliminate the solvents and subjected to the drying process for 24 h at 35 °C. This agrees with that reported by Wong-Paz et al. (2021)1 on the acetone solvent with greater efficiency for the extraction of the compounds of interest. Meaningfully, the dry purified acetone fraction has a concentration of fully condensed tannins corresponding to 0.20% based on dry coffee pulp, comparatively very similar to those reported by Wong-Paz et al. (2021)1 in concentration of procyanidins corresponding to 0.25% on coffee pulp. Traditionally, acetone is the most effective solvent in the extraction of condensed tannins, as its chemical composition and polarity are attractive, with only an interference in color development as it turns to that of the plant material used.19
3.2 Antibacterial activity of condensed tannins to implement as a natural preservative
The antibacterial evaluation (Table 1) of the condensed tannins reported an inhibitory capacity at 10 g L−1 against Salmonella typhimurium (16 ± 0.6 mm), Staphylococcus aureus (12 ± 0.5 mm) and Listeria monocytogenes (6 ± 0.1 mm). On the other hand, inhibition against Escherichia coli was not achieved under the conditions studied (Fig. 1). This is in contrast with the findings by Martins et al., (2020),4 who reported inhibition only against Gram-negative bacteria, including S. typhi and E. coli. The inhibitory effect observed against S. typhi can be attributed to differences in the type or concentration of the implemented procyanidin-rich fractions, the source material, etc. In recent years, antimicrobial resistance has become a global concern due to the increasing inefficiency of treatments against various pathogenic microorganisms, which has been attributed to various factors such as genetic mutations and horizontal transfer of resistance genes via mobile genetic elements such as plasmids and transposons.20,21 Although this study demonstrated antimicrobial effects of condensed tannins against several foodborne pathogens, no antimicrobial effect was observed against E. coli. This result highlights the persistent challenge against E. coli in the context of food safety, reaffirming the need for further research into natural food preservatives capable of targeting Gram-negative bacteria such as E. coli. Similarly, Medini et al., (2014)22 reported in their study that tannins obtained from the acetone fraction of the plant Limonium delicatulum did not present antimicrobial activity against E. coli. This contrasts with the finding that the condensed tannins extracted from coffee pulp show high antibacterial activity against some microorganisms related to ETAs.
Table 1 Antibacterial activity of condensed tannins against bacteria causing diseases transmitted in fooda
| g L−1 |
E. coli
|
S. typhi
|
S. aureus
|
L. monocytogenes
|
Ethanol 3% (−) |
Ampicillin (+) |
|
Antimicrobial activities were determined based on the diameter of the inhibition zone (mm). No inhibition (N).
|
| 1.0 |
N |
N |
N |
N |
N |
— |
| 5.0 |
N |
4.0 (±0.03) |
3.0 (±0.3) |
N |
N |
— |
| 10.0 |
N |
8.0 (±0.6) |
6.0 (±0.5) |
3.0 |
N |
13.0 (±0.01) |
|
| | Fig. 1 Antibacterial evaluation by the disc diffusion method with the following tannin concentrations: 1, 5 and 10 g L−1; negative (water) and positive (ampicillin) controls against bacteria such as S. typhi (A), L. monocytogenes, (B) S. aureus (C) and E. coli (D). | |
3.3 Shelf life of model food under controlled conditions with the implementation of natural and commercial preservatives
Bocoles were formulated following traditional specifications adapted for experimental conditions (5 cm diameter, 5 mm thickness, 25 g). These parameters were chosen based on shelf-life testing needs and aligned with reported traditional characteristics by Leary (2016);23 however, in our study, these characteristics were obtained for their elaboration in the size of 5 cm in diameter, 5 mm thick and 25 g in weight (Fig. 2). In this study, they were reduced because, for the shelf-life evaluation, a large amount of raw material was not required for the analyses. The precooking time and temperature were based on what was reported by Medina (2020)24 on the elaboration of bocoles from the Huasteca Potosina for their shelf-life in refrigerated packaging. The color of the natural bocol from the raw dough with lard was a characteristic cream color of the dough. The bocol with cottage cheese, made with the same materials but with the addition of this ingredient, was presented in white color. Finally, the beans bocol became light black. According to Leary (2016),23 who describes all the characteristic colors of each of the bocoles, these coincide with what was reported in this study.
 |
| | Fig. 2 Model food (bocol): without preservative (A), with commercial preservative (B), and with natural preservative (C). Three model food (bocol) were used: natural bocol (1), beans bocol (2), and cottage cheese bocol (3). | |
3.4 Choice of suitable packaging: polypropylene
The stability of food is affected by various factors, such as humidity, temperature, pH and water activity (aW), all of which are essential for assessing and predicting its shelf life. The parameters that were determined in this study for the analysis of the stability in each bocol were pH, aW and % H. The data obtained were analyzed in food stability graphs (Badui, 2006).16 These are used to evaluate the behaviour of foodstuffs in relation to their water activity and moisture content, linking them to physical, chemical and microbiological deterioration mechanisms. The X-axis of the graphs shows the water activity, while the Y-axis shows the moisture content. In addition, stability zones for different packaging such as high-density polyethylene, polypropylene, ethylene-vinyl-alcohol, etc. are included. Each graph includes curves indicating the activation ranges of different spoilage processes such as microbial growth (yeasts, bacteria and moulds), non-enzymatic browning reactions, lipid oxidation and enzymatic activity. The values of aW and % H of the different bocoles (natural, beans and cottage cheese) were plotted to locate their behaviour within the system. The relationship of pH with water activity, indicating the location of the food in the diagram, can be observed that the stability is acceptable for the 3 cases of food study (Fig. 3). In the case of natural bocoles, the pH and aW values recorded are in a zone of lower risk of microbial growth and enzyme activity, so that the thermal treatment of the packaging could be sufficient to ensure the stability of the food. On the other hand, the beans and cottage cheese bocoles have pH and aW, values within the most favorable ranges for microbial growth, especially yeasts and molds; for these specific cases the application of preservatives and adequate packaging is required to ensure their stability (Badui 2006).16 The material to be used in the study was determined, as this is essential for food storage, taking care that the packaging does not have an atmosphere of relative humidity higher than that of equilibrium, as this would cause a migration towards the interior of the food; therefore, the aW would increase.25 The experimental values of aW and % H obtained for the 3 bocoles plotted in the stability plots include reference zones of various materials as mentioned at the beginning of this section. The data points of the bocoles are within the plastic zone range, as the appropriate material to not present a migration of relative humidity, and thus did not suffer any factor outside the controlled ones such as temperature and time.
 |
| | Fig. 3 Changes in natural water activity-related bocol to determine appropriate packaging. Natural bocol, cottage cheese bocol and beans bocol (Badui, 2006).16 | |
The changes present in the bocol as a function of water activity in relation to the relative rate of reaction occur near the absorption isotherm, which describes the food being tested and the nearest deterioration, which is the enzyme activity. However, in this case, it is not possible to have an enzymatic activity because the food is precooked; therefore, it is expected that the enzymes have been eliminated.26 Due to the humidity of the food, the proliferation of fungi is very likely, so a barrier material is needed to prevent microbial growth in general. According to the results, the 3 types of processed bocoles: natural, cottage cheese and beans (Fig. 3) are presented within the aluminized polypropylene zone, compared to that reported by Medina et al., (2002)27 that determined the implementation of aluminized polypropylene because it is a type of plastic that does not contain bisphenol or phthalates, is resistant to corrosion, withstands high temperatures and its greatest attribute is the protection of food because it is able to maintain its nutrients for longer. Although aluminized polypropylene has demonstrated excellent barrier properties, its implementation was reconsidered in this study due to the prior incorporation of the condensed tannins (to verify with greater certainty its antibacterial activity and shelf-life extension) in the model food. As a result, the use of non-aluminized, vacuum-sealed polypropylene was selected, which allowed the quality of the food to be maintained and, at the same time, simplified the packaging requirements, giving preference to enhancing the effect of the condensed tannins, which is the focus of this research. It was determined that the appropriate packaging should be plastic with aluminized polypropylene; however, these plastics were not used because they are a high-cost material and difficult to obtain, so it was decided to use unaluminized and sealed polypropylene bags. Nguyen et al., (2021)28 reported in their study that the coating layers of polypropylene plastic significantly reduce the oxygen transmission of polypropylene packaging with 20 layers per layer of 60 mm thickness, decreasing approximately one hundred times, making the food does not present any interference of external factors for its high protection. This proves that the implementation of only polypropylene plastic packaging is suitable for this study.
3.5 Shelf life of model foods: natural bocol, cottage cheese bocol and beans bocol
The experimental design followed a mixed factorial scheme with repeated measures over time, and was carried out in stages. The food samples were taken from time 0 to 5 with a range of 3 days for the 5 times during storage at different temperatures of 2, 15 and 29 °C. Besides, three treatments were employed, without preservative (WP), with commercial preservative (CP) and with natural preservatives (NP). Samples were taken from the stored lots at appropriate time and temperature intervals, and at the same time pH, aW and % H were determined.
The analysis of the study data began by adjusting the incubator house temperature to calculate the kinetics. Then the reaction order for each phenomenon studied (pH, aW and % H) was determined for each type of bocol.
With the reaction order and its rate constant (k), the activation energy (Ea) was calculated using the Arrhenius equation. The calculation of the Ea allowed the prediction of the value of k at any T° (within the range studied) and the lifetime in days by the reaction order, which helped to understand the study in a simple way; for the search of specific data, the equation allows to predict it. Least squares were implemented, which allowed the adjustment to obtain a similar trend in the graphs, since the adjustment from the beginning was not possible to witness directly with the equation. Significantly, this is the first study that determines the shelf life of bocoles, so no reports were found for comparison; the most similar is the corn derivative that is tortillas, which were taken as a reference.
Activation energy (Ea) values and rate constants (k) were derived using the Arrhenius model, with k values ranging from −4.08 to −7.86 (log scale) (Table 2). All models showed strong correlations (R2 > 0.90), confirming the applicability of the kinetic approach, consistent with similar studies on maize tortillas for the lifetime of corn tortillas, with a high correlation (R2 > 0.92),29 when applying similar kinetic models. For natural bocoles, no significant differences in pH or shelf life were observed among treatments (WP, CP, and NP), likely due to the simple matrix of corn dough and lard. However, temperature had a clear influence: lower temperatures prolonged shelf life, as similarly reported by Calderon-Perez et al. (2019)30 for refrigerated storage. In the cottage cheese bocoles, the pH decreased more steeply, being a product with higher protein and moisture content, due to the inclusion of a dairy product.
Table 2 Shelf-life data of natural bocol (NB), beans bocol (BB) and requeson bocol (RB) from the kinetics reactions based on pH without and with preservatives
| |
Without preservative |
Without commercial preservative |
Natural conservative |
Unit |
| NB |
BB |
CC |
NB |
BB |
CC |
NB |
BB |
RB |
|
T
0
|
0.0036 |
0.0036 |
0.0036 |
0.0036 |
0.0036 |
0.0036 |
0.0036 |
0.0036 |
0.0036 |
K−1 |
|
E
a/R |
−4880.14 |
−5844.49 |
−13 568.12 |
−4718.26 |
−3844.49 |
−5769.19 |
−4342.28 |
−3621.18 |
−5489.32 |
K |
| K |
−5.12 |
−5.93 |
−5.97 |
−5.68 |
−5.69 |
−5.75 |
−4.56 |
−4.84 |
−6.53 |
|
| pH0 |
5.75 |
5.72 |
5.66 |
5.72 |
5.72 |
5.76 |
5.90 |
5.72 |
5.77 |
|
| pHF |
5.60 |
5.65 |
5.60 |
5.60 |
5.62 |
5.62 |
5.54 |
5.50 |
5.61 |
|
|
R
2
|
0.9739 |
0.99 |
0.96 |
0.99 |
0.99 |
0.95 |
0.92 |
0.99 |
0.97 |
|
The protein in the cottage cheese, especially lactoglobulin and lactalbumin, which have a higher biological value than casein,31 directly influenced the rate of spoilage. In this case, statistically significant differences were observed between WP and preservative treatments, while NP and CP showed similar behaviors, indicating that condensed tannins may exert a comparable function to synthetic preservatives. Furthermore, Mazorra et al. (2019)32 reported that cottage cheese contains between 4 and 13% protein and a high-water content, which supports the need to include additives to improve its stability. As shown in Fig. 4, the effect of each study is observed. First the cottage cheese bocoles showed a sharper decline in pH due to their higher protein and moisture content. Statistically significant differences were observed between the control and preservative-treated groups, with NP and CP treatments yielding similar shelf-life extensions. This indicates that condensed tannins can match the effectiveness of commercial preservatives in high-protein matrices.
 |
| | Fig. 4 Data on the shelf life of natural bocol (A), cottage cheese bocol (B) and beans bocol (C) from the kinetic reactions based on pH without and with commercial and natural preservatives. | |
Finally, beans bocol was identified as the most perishable matrix, reflected in a more rapid reduction in pH. Despite its nutritional potential for supplementing limiting amino acids of corn (lysine and methionine), its higher content of complex carbohydrates, such as hemicellulose,16 increased its vulnerability to physical and microbiological changes. Among the three variants, beans bocoles were the most perishable, as evidenced by rapid pH decline. Their high content of complex carbohydrates and water made them particularly susceptible to microbial and physicochemical degradation. Both CP and NP treatments significantly improved shelf life compared to the control, aligning with findings by Valero and Pérez (2009)33 on post-cooked beans.
These results indicate that, while natural bocol did not show a significant benefit from the use of preservatives, the cottage cheese and beans formulations did, due to their greater compositional complexity and higher risk of spoilage. The antimicrobial and antioxidant properties of the condensed tannins contributed significantly, especially at temperatures of 18 °C to 40 °C (Fig. 4), showing an effect comparable to that of synthetic preservatives (Table 3).
Table 3 Statistical comparisons of the shelf life of model foods
| Type of bocol |
WP vs. CP (α) |
WP vs. NP (α) |
CP vs. NP (α) |
| Natural |
0.0975 |
0.8362 |
0.1203 |
| Cottage cheese |
0.0399 |
0.0277 |
0.8986 |
| Beans |
0.0005 |
0.0004 |
0.9119 |
Notably, the importance of the application of the zero-order kinetic model based on pH proved to be a useful tool for predicting shelf life. Furthermore, the efficacy of condensed tannins as a natural preservative was demonstrated, especially in products with higher susceptibility to spoilage, positioning them as a promising and cost-effective alternative for the stabilization of traditional maize-based foods.
4. Conclusions
This study demonstrated the antimicrobial activity of condensed tannins extracted from coffee pulp (Coffea arabica), particularly against foodborne pathogens such as S. aureus, S. typhimurium, and L. monocytogenes. Their performance in extending shelf life in model foods was comparable to that of synthetic preservatives (sodium benzoate and potassium sorbate), especially in formulations containing beans or cottage cheese. In contrast, natural bocoles showed no significant shelf-life extension under any treatment, likely due to their low compositional complexity. These findings support the viability of condensed tannins as natural preservatives for complex food matrices. Their application responds to growing consumer demand for clean-label products and additive-free preservation methods. Future research should focus on evaluating the toxicological safety, sensory impact, and regulatory feasibility of incorporating tannins into commercial food systems.
Author contributions
Sandy R. Garcia-Rodriguez: as the first author, investigation, data extraction, methodology, validation, and writing of the original manuscript. Hector Reynoso-Ponce: writing, data validation, review, editing, and visualisation. Imad Khan: data analysis, writing, review, and editing. Muneeba Naseer Chaudhary: writing, review, editing, and visualisation. Diana B. Muñiz-Márquez: writing, review and editing. Abigail Reyes-Munguía: writing, review and editing. Martina de la Rosa-Hernández: writing, review and editing. Jorge E. Wong-Paz: supervision, writing, review, editing, conceptualisation, funding acquisition, visualisation and investigation.
Conflicts of interest
The authors declare no conflicts of interest
Data availability
The data supporting the findings of this research are available in the article.
Acknowledgements
This research did not receive any specific grants from funding agencies in the public, commercial, or not-for-profit sectors.
Notes and references
- J. E. Wong-Paz,
et al., Structural characterization of native and oxidized procyanidins (condensed tannins) from coffee pulp (Coffea arabica) using phloroglucinolysis and thioglycolysis-HPLC-ESI-MS, Food Chem., 2021, 340, 127830 CrossRef CAS PubMed.
- C. Li,
et al., Contribution of microbial community to flavor formation in tilapia sausage during fermentation with Pediococcus pentosaceus, Lebensm.-Wiss. Technol., 2022, 154, 112628 CrossRef CAS.
- M. Ruiz-Rico,
et al., Impact of food preservatives based on immobilized phenolic compounds on an in vitro model of human gut microbiota, Food Chem., 2023, 403, 134363 CrossRef CAS PubMed.
- G. R. Martins,
et al., Chemical characterization, antioxidant and antimicrobial activities of açaí seed (Euterpe oleracea Mart.) extracts containing A- and B-type procyanidins, Lebensm.-Wiss. Technol., 2020, 132, 109830 CrossRef CAS.
- R. Castro-Díaz, N. P. Silva-Beltrán, N. Gámez-Meza and K. Calderón, The Antimicrobial Effects of Coffee and By-Products and Their Potential Applications in Healthcare and Agricultural Sectors: A State-of-Art Review, Microorganisms, 2025, 13, 215 CrossRef.
-
N. Mohammed, R. Al-Ani, A. Abd-alhameed and S. Mohammed, Antibacterial Activity of Tannins Extracted from Some Medicinal plants in vitro, 2008 Search PubMed.
- S. Mamur, D. Yüzbaşıoğlu, F. Ünal and H. Aksoy, Genotoxicity of food preservative sodium sorbate in human lymphocytes in vitro, Cytotechnology, 2012, 64, 553 CrossRef CAS PubMed.
- A. Masyita,
et al., Terpenes and terpenoids as main bioactive compounds of essential oils, their roles in human health and potential application as natural food preservatives, Food Chem.: X, 2022, 13, 100217 CAS.
- G. Y. Kim,
et al., Effect of Antioxidant Addition on Milk Beverage Supplemented with Coffee and Shelf-life Prediction, Food Sci. Anim. Resour., 2019, 39, 903 CrossRef PubMed.
- J. H. Park, D. S. An, D. S. Lee and E. Park, Prediction of Shelf-life of Sea Tangle Drink, J. Korean Soc. Food Sci. Nutr., 2014, 43, 784–790 CrossRef.
- M. A. Ramirez-Coronel,
et al., Characterization and Estimation of Proanthocyanidins and Other Phenolics in Coffee Pulp (Coffea, arabica) by Thiolysis-High-Performance Liquid Chromatography, J. Agric. Food Chem., 2004, 52, 1344–1349 CrossRef CAS PubMed.
- H. C. Zhou, Y. M. Lin, S. D. Wei and N. F. Y. Tam, Structural diversity and antioxidant activity of condensed tannins fractionated from mangosteen pericarp, Food Chem., 2011, 129, 1710–1720 CrossRef CAS.
- H. C. Zhou,
et al., Relationships between degree of polymerization and antioxidant activities: A study on proanthocyanidins from the leaves of a medicinal mangrove plant Ceriops tagal, PLoS One, 2014, 9, 0107606 CrossRef.
- L. J. Porter, L. N. Hrstich and B. G. Chan, The conversion of procyanidins and prodelphinidins to cyanidin and delphinidin, Phytochemistry, 1985, 25, 223–230 CrossRef.
-
F. Cockerill and Clinical and Laboratory Standards Institute, Methods for Dilution Antimicrobial Susceptibility Tests for Bacteria that Grow Aerobically: Approved Standard, Clinical and Laboratory Standards Institute, 2012 Search PubMed.
-
S. Badui, Salvador Badui Dergal, Química de los alimentos, 2006 Search PubMed.
- H. Myo and N. Khat-udomkiri, Optimization of ultrasound-assisted extraction of bioactive compounds from coffee pulp using propylene glycol as a solvent and their antioxidant activities, Ultrason. Sonochem., 2022, 89, 106127 CrossRef CAS.
- M. S. Alkaltham, A. Salamatullah and K. Hayat, Determination of coffee fruit antioxidants cultivated in Saudi Arabia under different drying conditions, J. Food Meas. Char., 2020, 14, 1306–1313 CrossRef.
- T. H. Terrill, A. M. Rowan, G. B. Douglas and T. N. Barry, Determination of extractable and bound condensed tannin concentrations in forage plants, protein concentrate meals and cereal grains, J. Sci. Food Agric., 1992, 58, 321–329 CrossRef CAS.
- C. Ronald, J. W. Matofari and J. M. Nduko, Antimicrobial resistance of E. coli strains in ready-to-eat red meat products in Nakuru County, Kenya, Microbe, 2023, 1, 100022 CrossRef.
- S. Asadi, M. Kargar, K. Solhjoo, A. Najafi and S. Ghorbani-Dalini, The association of virulence determinants of uropathogenic Escherichia coli with antibiotic resistance, Jundishapur J. Microbiol., 2014, 7, e9936 Search PubMed.
- F. Medini, H. Fellah, R. Ksouri and C. Abdelly, Total phenolic, flavonoid and tannin contents and antioxidant and antimicrobial activities of organic extracts of shoots of the plant Limonium delicatulum, J. Taibah Univ. Sci., 2014, 8, 216–224 CrossRef.
-
G. P. Leary, Hoy le canto a mi sustento, romance para el sabor de la mesa huasteca, 2016, pp. 253–255, Creative Commos, ISBN: 978-607-502-295-6 Search PubMed.
-
M. A. Medina, Bocoles, delicia de la Huasteca Potosina, 2020, https://www.elsoldesanluis.com.mx/local/bocoles-delicia-de-la-huasteca-potosina-5610773.html Search PubMed.
- S. Zardetto, A. Dal Martello and G. Pasini, Moisture migration model of packed fresh-filled pasta during storage under different humidity conditions, Innovative Food Sci. Emerging Technol., 2025, 100, 103930 CrossRef CAS.
- J. Pérez-Calderon, A. Califano, M. V. Santos and N. Zaritzky, Kinetic Parameters for the Thermal Inactivation of Peroxidase and Lipoxygenase in Precooked Frozen Brassica Species, J. Food Sci., 2017, 82(6), 1378–1386 CrossRef.
- C. L. Medina, R. P. Souza, E. C. Machado, R. V. Ribeiro and J. A. B. Silva, Photosynthetic response of citrus grown under reflective aluminized polypropylene shading nets, Sci. Hortic., 2002, 96, 115–125 CrossRef.
- H. L. Nguyen,
et al., Biorenewable, transparent, and oxygen/moisture barrier nanocellulose/nanochitin-based coating on polypropylene for food packaging applications, Carbohydr. Polym., 2021, 271, 118421 CrossRef CAS PubMed.
- I. Y. Meléndez Pastrana,
et al., Determinación de la vida útil de la tortilla de maíz adicionada con aceite esencial de tomillo a través de pruebas de vida acelerada, RIDE. Rev. Iberoam. Investig. Desarro. Educ., 2021, 12, 20077467 Search PubMed.
- J. Calderon-Perez, M. V. Santos and N. Zaritzky, Processing of pre-cooked frozen Brussels sprouts: Heat transfer modelling as related to enzyme inactivation and quality stability, Food Bioprod. Process., 2019, 114–129 CrossRef.
- E. M. Hubbard, S. M. Jervis and M. A. Drake, The effect of extrinsic attributes on liking of cottage cheese, J. Dairy Sci., 2016, 99, 183–193 CrossRef CAS PubMed.
- M. Á. M. Mazorra, H. Ramírez Montejo, M. E. Lugo Sánchez, A. F. González Córdova and B. Vallejo Córdoba, Caracterización del lactosuero y requesón proveniente del proceso de elaboración de queso cocido (asadero) región Sonora, Nova Scientia, 2019, 11, 220–233 CrossRef.
- M. Granito, Y. Valero and S. Pérez, Vida útil de granos Phaseolus Vulgaris L. fermentados y listos para el consumo., Rev. Fac. Agron., 2009, 26(1), 88–106 Search PubMed.
|
| This journal is © The Royal Society of Chemistry 2026 |
Click here to see how this site uses Cookies. View our privacy policy here.